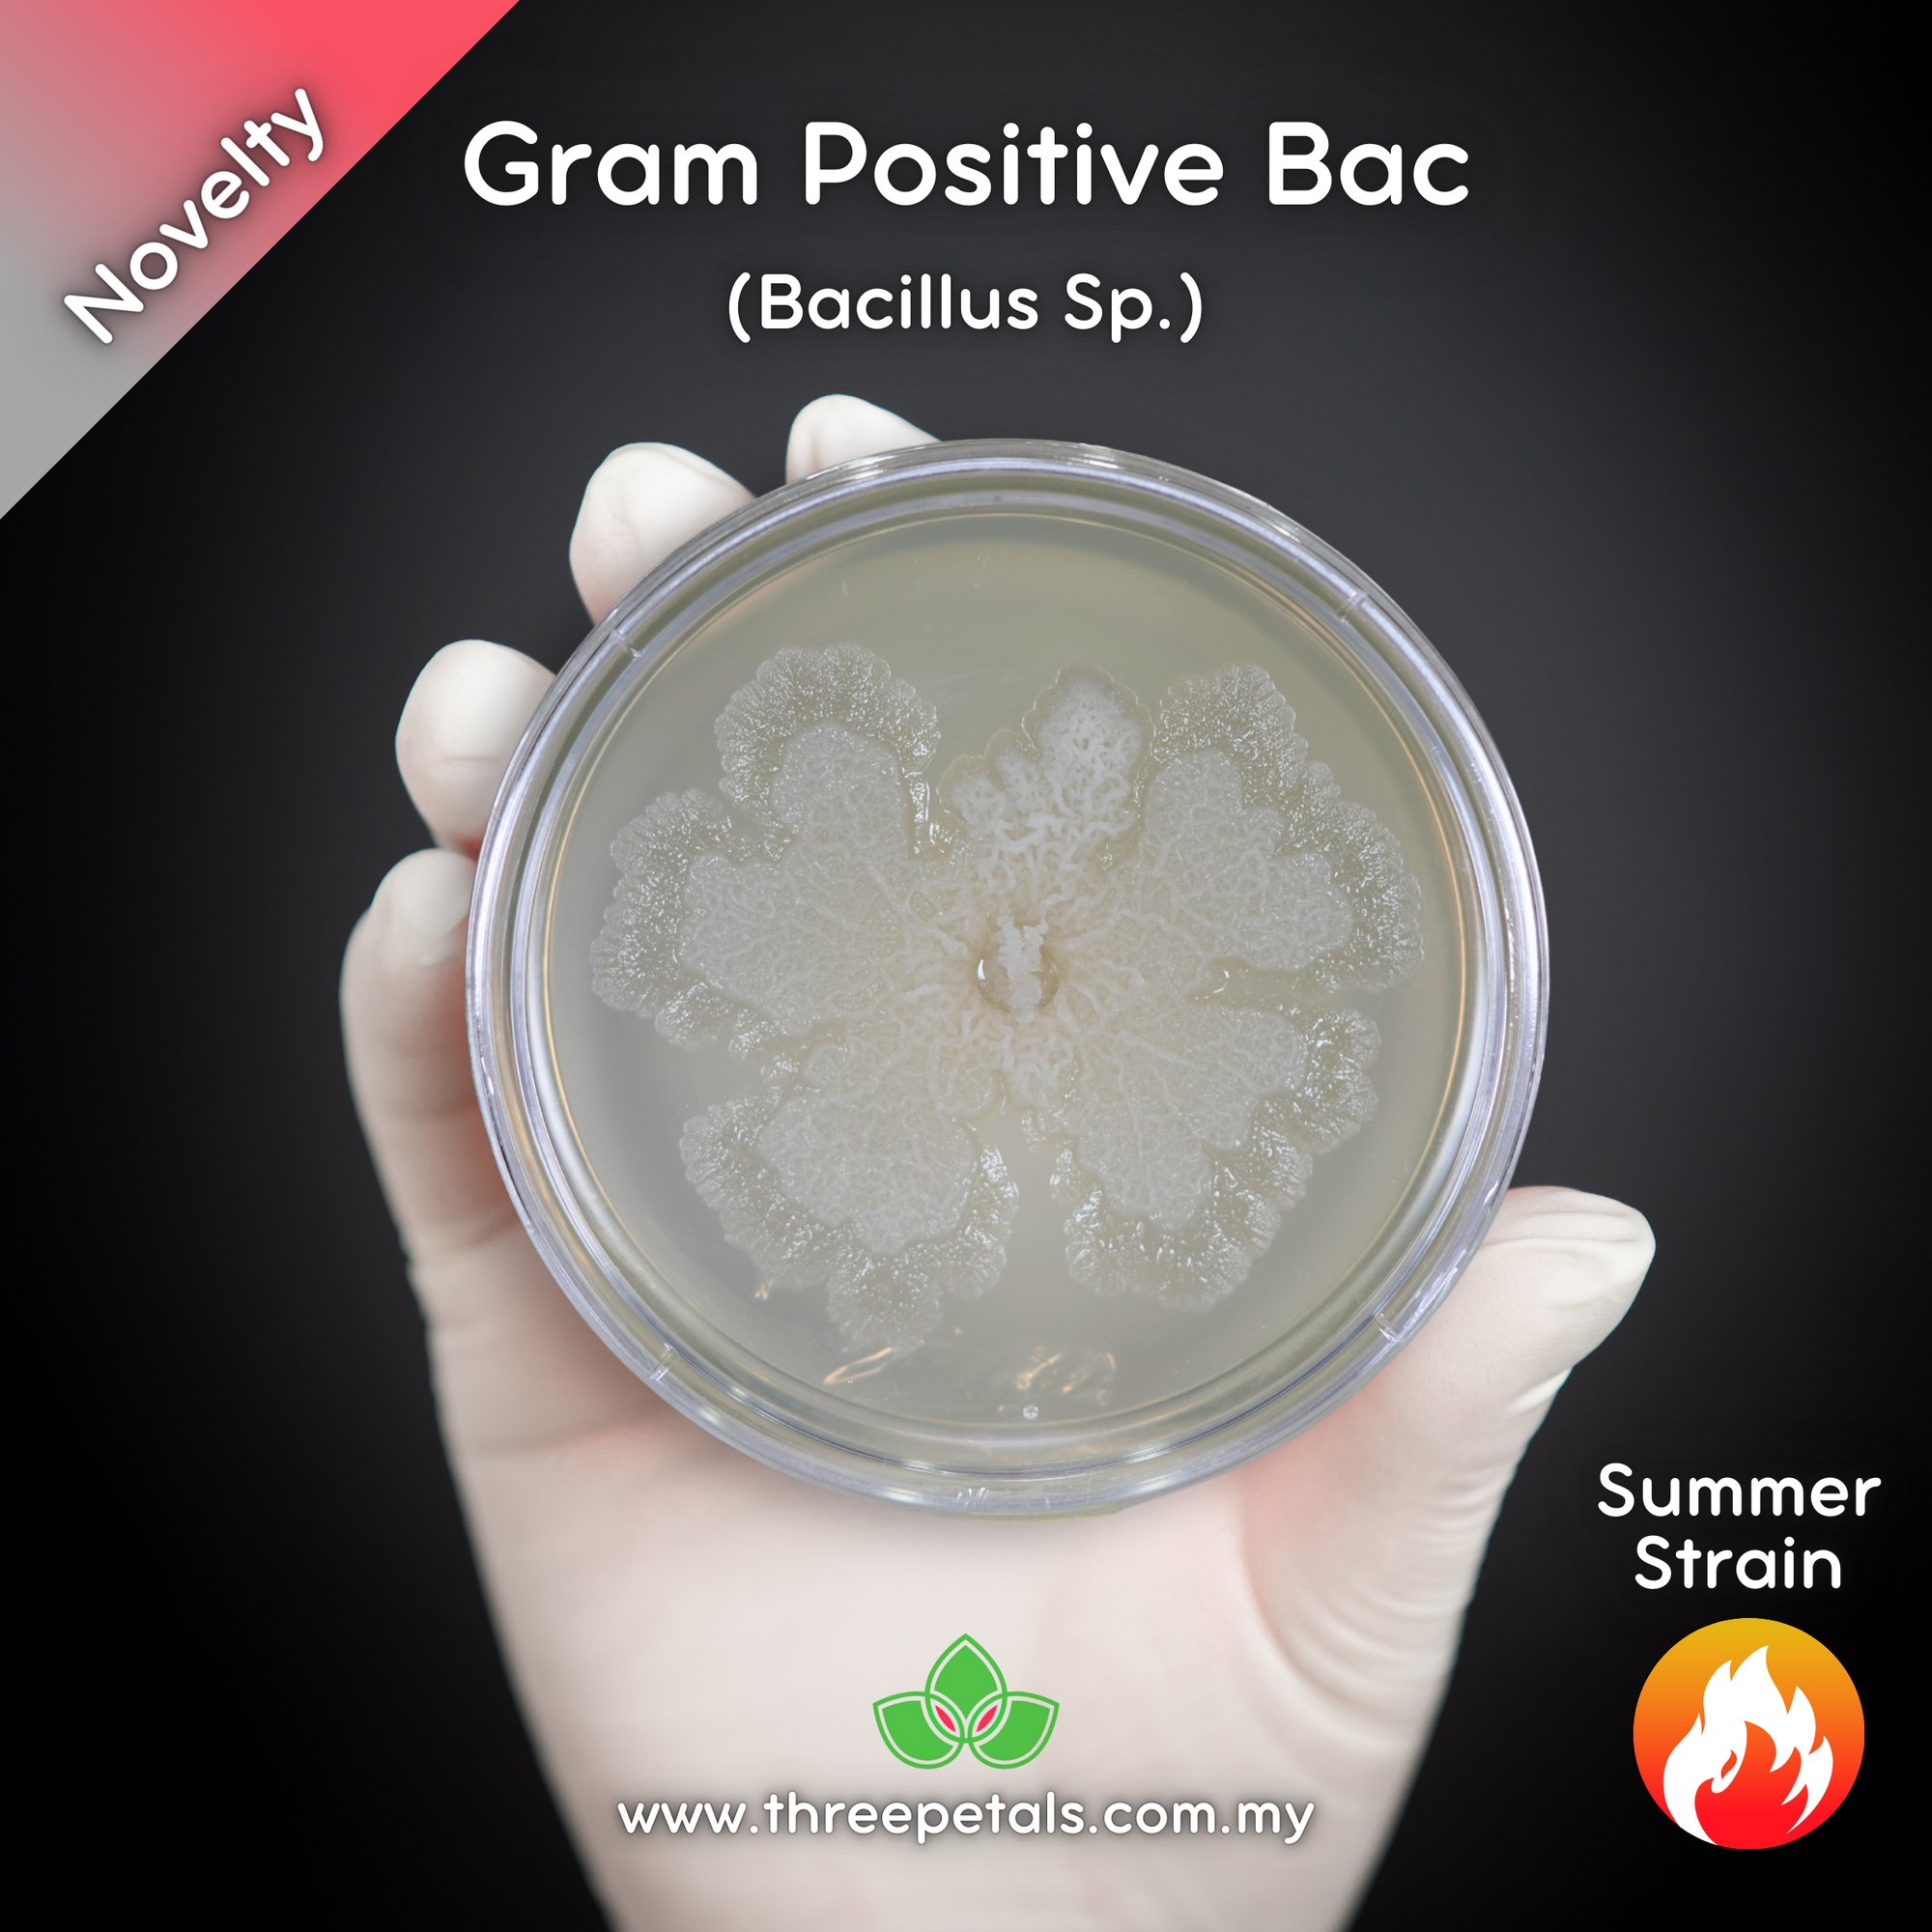

Gram Positive Bacteria (Bacillus Sp.) Live Mycelium Mushroom Culture Spawn
RM 118.00

DETAILS
* Species - Gram Positive Bacteria (Bacillus Sp.)
* Strain - Summer
* Vessel - Petri
* Size - 90mm X 15mm
* Media - Malt Extract Agar (MEA)/Colored
* Usage - Can be expanded to other petri plates, grain spawn, and liquid cultures!
IMPORTANT
* User must be familiar with microbiology/mycology prior to usage
* Item is best to be used fresh
* Item must be kept in cold storage for long term viability